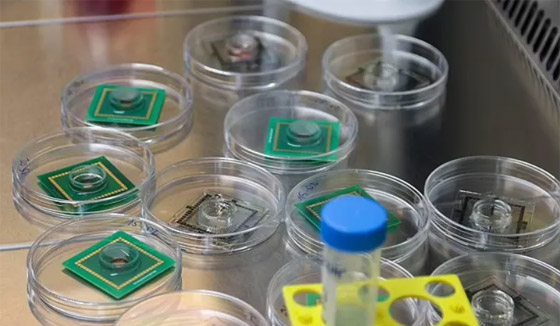
علماء يصنعون كمبيوترا خارقا من خلايا دماغ بشري صورة رقم 4 علماء يصنعون كمبيوترا خارقا من خلايا دماغ بشري صورة رقم 4

علماء يصنعون كمبيوترا خارقا من خلايا دماغ بشري
نجحت مجموعة من العلماء في تحويل الخيال العلمي إلى حقيقة، حيث نجحوا في استخدام خلايا من دماغ الإنسان في صناعة جهاز كمبيوتر بمواصفات وإمكانات خارقة، وهو ما يُمكن أن يُطلق عليه اسم "كمبيوتر حي" أو "كمبيوتر حيوي" بسبب ذكائه الكبير والمأخوذ من الإنسان.
وتم التوصل إلى هذا الابتكار في السويد، حيث يقول العلماء إنهم تمكنوا من زراعة خلايا الدماغ البشري في المختبر واستخدموها في إنتاج هذا الكمبيوتر الذكي. ويقول العلماء إن هذا الجهاز الخارق من الممكن أن ينجح في التغلب على أزمة الطاقة التي يعاني منها العالم. الجهاز يتألف من 16 جزءا عضويا، أو كتل من خلايا الدماغ التي تمت زراعتها في المختبر، والتي ترسل المعلومات فيما بينها.

وتعمل هذه الأجزاء بشكل يشبه إلى حد كبير شريحة الكمبيوتر التقليدية، حيث ترسل وتستقبل الإشارات من خلال خلاياها العصبية التي تعمل مثل الدوائر، لكن ما يجعلها مميزة هو أن الآلة الحية تستخدم طاقة أقل لأن الخلايا العصبية الحية يمكنها استخدام طاقة أقل بمليون مرة من المعالجات الرقمية الحالية المستخدمة حالياً.
وعند مقارنة الجهاز الجديد بأفضل أجهزة الكمبيوتر في العالم وجد العلماء أنه بنفس السرعة وذاكرة أكبر بواقع ألف مرة، كما أنه يتفوق على الدماغ البشري الذي يستخدم ما بين 10 و20 واط، مقارنة بالكمبيوتر الذي يستخدم 21 ميغاوات. وتم تطوير هذا الكمبيوتر الحي من قبل العلماء في شركة "فاينال سباركس" التي تركز على إيجاد حلول مع الشبكات العصبية البيولوجية.

وقال الدكتور فريد جوردان، الرئيس التنفيذي المشارك لشركة "فاينال سبارك"، وهي شركة ناشئة تركز على إيجاد حلول للشبكات العصبية البيولوجية، إن هذه الفكرة شائعة في الخيال العلمي، ولكن لم يكن هناك قدر كبير من الأبحاث الحقيقية حولها. ويقول إن "العضوانيات" التي تم استخدامها في تطوير الجهاز هي عبارة عن مزارع أنسجة صغيرة ثلاثية الأبعاد ذاتية التنظيم مصنوعة من الخلايا الجذعية.
وتم بناء أدمغة "فاينال سباركس" الصغيرة مما يقدر بنحو عشرة آلاف خلية عصبية حية، يبلغ قطرها حوالي 0.5 ملم. ويتم تدريب الكائنات العضوية، وعندما تؤدي المهام بشكل صحيح، فإنها تحصل على تدفق من المادة الكيميائية كمكافأة. ومن المعروف أن العالم يواجه أزمة طاقة بسبب نقص الوقود وتعطل سلاسل التوريد والتوترات الجيوسياسية والانتقال إلى الطاقة المتجددة. ناهيك عن صعود الذكاء الاصطناعي الذي من المتوقع أن يستخدم 29.3 تيراواط ساعة سنوياً (تيراواط واحد يساوي تريليون واط)، حيث يقول العلماء إن هذا الكمبيوتر الحيوي قد يقضي على هذه الأزمة.

للتواصل معنا
للتواصل معنا 